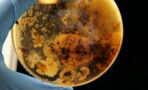
Spezialist glaubt, die NASA könnte den Mars kontaminiert haben

Ist es ein Flugzeug? Ist es eine fliegende Untertasse oder doch nur ein Vogel? Als die Internationale Raumstation (ISS) über Südostasien schwebt, macht ein Astronaut an Bord der Station ein seltsames Foto von der Erde. Der blaue Planet sieht aus wie immer, aber zu sehen sind auch zwei bläuliche Kugeln, die in der Atmosphäre glitzern.
Zwei Objekte über der Erde
Sind diese nicht identifizierbaren Objekte aus einer anderen Welt gekommen, um die Erde zu besiedeln? Natürlich ist es verlockend, so etwas zu glauben, doch die Realität sieht anders aus: Das Foto, das vom Earth Observatory der NASA am 9. Oktober veröffentlicht wurde, nahm letztes Jahr ein Mitglied der Expedition 66 Crew auf.
Wir sehen auf dem Foto die Erde vom Weltraum aus, wie sie von ihren Sternen umgeben ist. Wir sehen die Lichter der Städte, die Verkehrsachsen der großen Ballungsgebiete und einige Wolken.
An astronaut aboard the @Space_Station took this photo of Earth’s limb – where Earth’s atmosphere meets space – over the nighttime lights of Thailand and Vietnam in 2021.
— NASA Earth (but haaaunted 👻) (@NASAEarth) October 10, 2022
A flash of lightning illuminates passing storm clouds at the bottom of the image. ⚡https://t.co/DofiAbUqD2pic.twitter.com/6TjD5tEbTq
Was ist auf dem Foto zu sehen?
Aber das ist noch nicht alles. Zwei blaue Objekte erstrahlen in diesem Bild. Der erste befindet sich über dem asiatischen Golf von Thailand, der zweite am Horizont in Richtung des Südchinesischen Meeres. Was kann das sein? Leider sind das keine Außerirdischen, die wir am Horizont sehen. Nur ein paar seltene meteorologische und astronomische Phänomene, aber das war's auch schon.
Tero Mielonen, leitender Wissenschaftler am Zentrum für Atmosphärenforschung des Finnischen Meteorologischen Instituts, erklärt gegenüberNewsweek, dass einige der Blitze, die in den Wolken geladen sind, nie den Boden erreichen. Sie bleiben also manchmal in den Wolken gefangen und werfen dann dieses Licht um sie herum.
Kein UFO in Sicht
Aber was ist dann das andere Licht? Es handelt sich um das Licht des Mondes, einfach nur vom Weltraum aus betrachtet. Der Streueffekt ist auch der Grund dafür, dass der Himmel am Tag blau erscheint.
Das Licht, das über den sogenannten Äther gelangt, (Bezeichnung für die Ausbreitung des Lichts in Vakuum wie dem Weltall) kehrt blau zu uns zurück. Laut Live Science beeinflusse die Ausrichtung des Mondes in Bezug auf die ISS die Art und Weise, wie das Licht von der Sonne reflektiert wird, wenn es die Atmosphäre des Planeten durchdringt.
Auch interessant:
⋙ Nach sechs Monaten im All: Der deutsche Astronaut Matthias Maurer ist wieder auf der Erde!
⋙ UFOs: Die erschreckenden Enthüllungen der ersten britischen Astronautin
⋙ Dieser Astronaut kehrt komplett verändert aus dem All zurück
Aus dem Französischen übersetzt von Gentside Frankreich